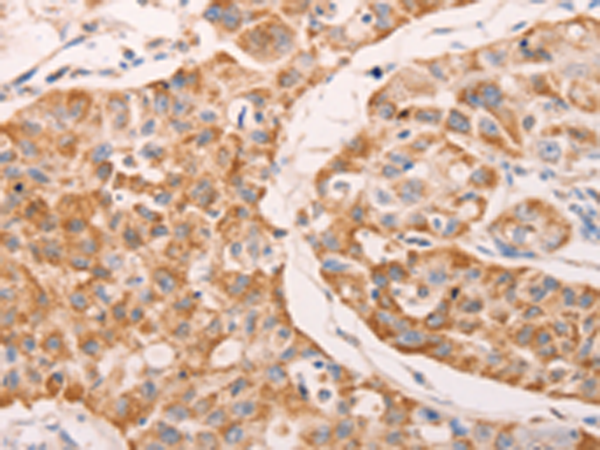
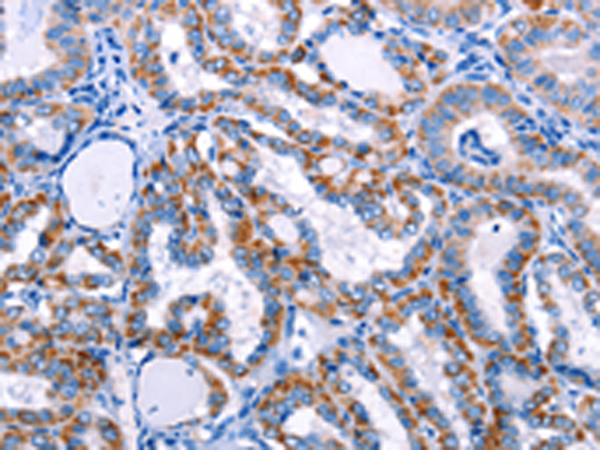
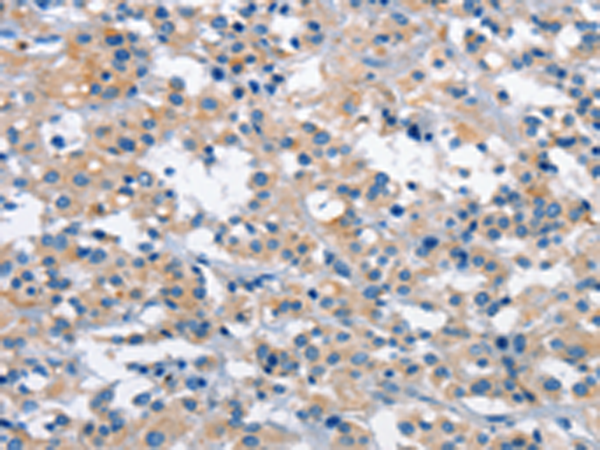

-
分类: 科研抗体货号: P07284别名: TYP, HVH2, MKP2, MKP-2应用: WB,IHC反应种属: Human, Mouse, Rat
-
分类: 科研抗体货号: P07305别名:应用: WB,IHC反应种属: Human, Mouse, Rat
-
分类: 科研抗体货号: P07315别名: PDF; MIC1; PLAB; MIC-1; NAG-1; PTGFB; GDF-15应用: IHC反应种属: Human
-
分类: 科研抗体货号: P07302别名: AHO, GSA, GSP, POH, GPSA, NESP, GNAS1, PHP1A, PHP1B, PHP1C, C20orf45应用: WB,IHC反应种属: Human, Mouse, Rat
-
分类: 科研抗体货号: P07313别名: KEC; KS1; BMAC; BRAK; NJAC; MIP2G; MIP-2g; SCYB14应用: IHC反应种属: Human
-
分类: 科研抗体货号: P07301别名: GNA-11应用: WB,IHC反应种属: Human, Mouse, Rat
-
分类: 科研抗体货号: P07312别名: GRO3; GROg; MIP2B; SCYB3; MIP-2b; CINC-2b应用: IHC反应种属: Human
-
分类: 科研抗体货号: P07300别名: FRA3B, AP3Aase应用: WB,IHC反应种属: Human, Mouse, Rat
-
分类: 科研抗体货号: P07311别名:应用: WB,IHC反应种属: Human, Mouse
-
分类: 科研抗体货号: P07329别名: IT11; GPRK4; GRK4a; GPRK2L应用: WB,IHC反应种属: Human

鄂公网安备42018502007531号
鄂公网安备42018502007531号

